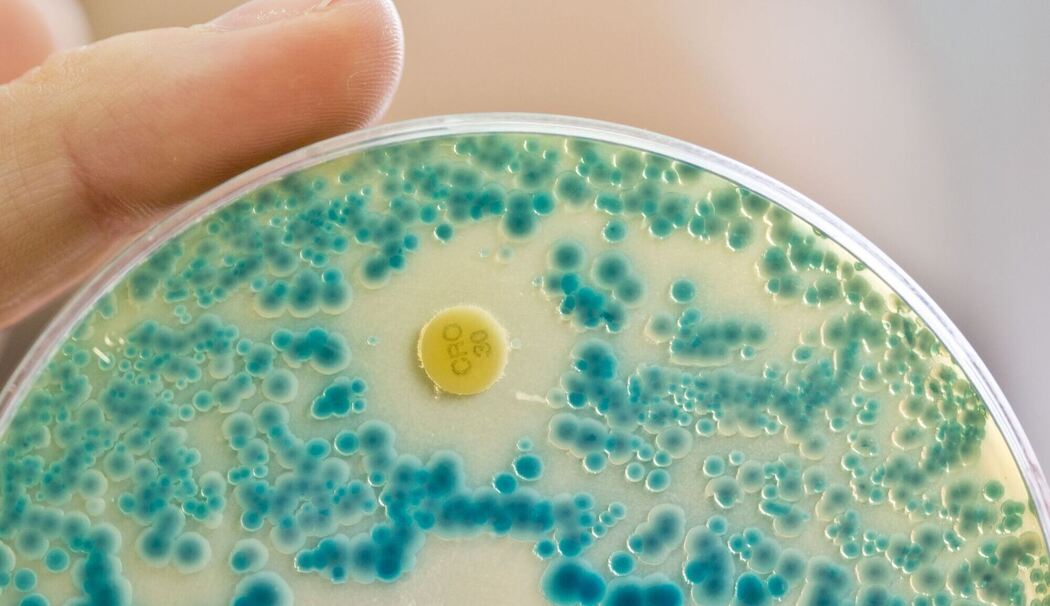

Antibiotika sind Wundermittel in der Medizin. Sie helfen dabei, schnell gesund zu werden, wenn bestimmte Bakterien den Körper krank machen. Fachleute berichteten am Montag aber: Immer mehr Bakterien können sich inzwischen gegen Antibiotika wehren. Hier beantworten wir einige Fragen dazu.
Was ist ein Antibiotikum?
»Es gibt winzig kleine Lebewesen, die man mit dem Auge nicht sehen kann. Diese heißen Bakterien und können uns krank machen«, erklärt Professor Volkhard Kempf. Er ist Fachmann für Bakterien. Antibiotika wiederum sind Medikamente, die diese Bakterien im Körper bekämpfen. Sie helfen also, Menschen gesundzumachen. Ihre Entdeckung vor ungefähr 100 Jahren rettet seitdem vielen Menschen das Leben.
Wogegen helfen Antibiotika?
Antibiotika helfen bei Entzündungen im Körper, die durch Bakterien verursacht wurden. Es gibt verschiedene Antibiotika. Sie sind auf bestimmte Bakterien spezialisiert und bekämpfen sie. Wenn man starke Halsschmerzen hat, bekommt man ein anderes Antibiotikum, als bei einer Wunde am Bein.
Was bedeutet Resistenz?
Manche Bakterien lernen dazu, Resistenz heißt das. Der Fachmann erklärt: »Resistenzen kann man sich so vorstellen: Wenn Bakterien eine Ritterrüstung anlegen, sind sie gegen Antibiotika geschützt. Dann können sie nicht bekämpft werden«. Die Antibiotika verlieren also ihre heilende Wirkung. Die Forschung arbeitet deshalb ständig daran, neue Antibiotika zu entwickeln.
Wie schützt man sich?
Händewaschen oder die Benutzung von Desinfektionsgel schützen vor der Ansteckung mit Bakterien. Aber wenn man schlimm krank ist, entscheidet der Arzt oder die Ärztin, ob man ein Antibiotikum bekommt. Der Fachmann sagt: »Es sollten auch Untersuchungen im Labor durchgeführt werden. So kann der Arzt sicherstellen, dass die Antibiotika wirklich die richtigen sind.«
© dpa-infocom, dpa:251013-930-156319/1